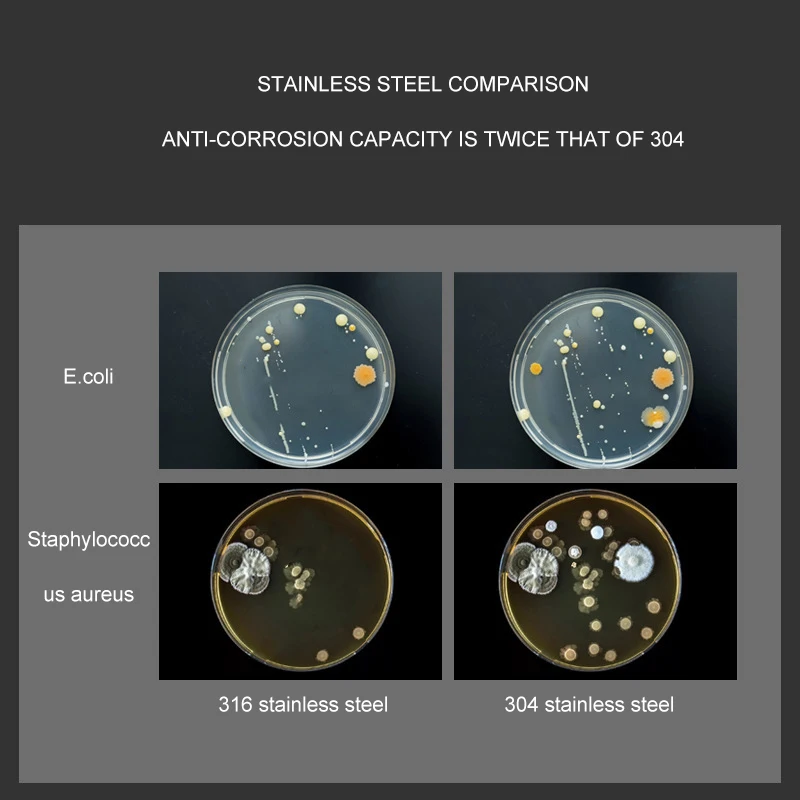
thumb

Сковорода с антипригарным покрытием без масла, сковорода с антипригарным покрытием, индукционная плита без покрытия, универсальный газ, нержавеющая сталь 316
   Price history chart & currency exchange rate
Customers also viewed

$35.90
UNLEASHIA Satin Wear Healthy-Green Cushion Кушон с сатиновым финишем, Satin Wear Healthy-Green Cushion Кушон с сатиновым финишем
letu.ru
$268.54
Иллюстрация плененного эльфа от Кекемоцу, нарисованная полная фигура, не масштабированная, ПВХ и АБС
joom.ru
$10.66
Подвеска для зеркала заднего вида автомобиля, вязаная крючком корзина для цветов, горшечное растение, подвесное украшение, украшение для интерьера автомобиля
joom.ru
$768.11
Элитный рыбопоисковый эхолот FS 7 с активным изображением 3-в-1, предварительно загруженный зеркальный контур + диаграммы
aliexpress.ru
$2.29
Золотая фольга, стикер для ногтей, рельефный дизайн, очаровательные винтажные Стикеры для ногтей, Стикеры для УФ-отверждения, элегантные наклейки для ногтей
aliexpress.ru
$57.94
Новое масло коробки передач для Z4 E82 E88 E89 E90 E92 E93 F06 F10 F12 F13 F80 F82 28107842385 28108070791
aliexpress.ru
$57.33
shoes shoes&sandals authentic shoes 1 1s 85 panda black white bq4422-001 shoes original 5.5-13
dhgate.com
$9.84
2019 new fashion white balck money clip wallet for women pink Mobile phone coin holder clutch wallets for girls o bag
aliexpress.com
$8.99
Sexy Two Piece Sets Summer Women 2019 Midi Elegant Package Hip Beach Long Skirts and Solid Tank Strapless Bodycon Pencil Skirt
aliexpress.com
$20.63
Women Flare Sleeve Pleated Polka Dot Tulle Mesh Gauze Voile Bow Dress Casual Hollow Out Lace Flower Bandage Strap Ruffles Dress
aliexpress.com
$15.11
Colorful Striped Print Blazer Dress 2019 Autumn Vintage Long Sleeve Mini Bodycon Dress Fashion Office Dress Vestidos De Fiesta
aliexpress.com
$3.73
Classic Serpentine Small leather Handbags Women Crossbody bags lock design Ladies Mini shoulder Messenger bags Sac a main
aliexpress.com
$0.99
Iron Man Infinity Glove Endgame Thor Captain America Hawkeye Pepper MK 2 Armor Building Blocks Toys WM658 kIDS
aliexpress.com
$1.69
2PCS Asus ZenFone 3 Zoom ZE553KL Glass Phone Screen Protector Tempered Glass For Asus ZenFone 3 Zoom ZE553KL Front Film BSNOVT
aliexpress.com
$45.96
2018 Winter Imitation Fox Fur Stitching Jacket Coat Women Faux Fur Hooded Jackets Fashion Female Thicken Jackets Warm Outerwear
aliexpress.com
$38.07
New 2019 Autumn Winter High Quality Runway Office Lady 2 Pieces Set Bow Pocket Top Straight Skirt Thick Chic Twin Set Tracksuit
aliexpress.com
$12.53
Hollow Push Up Bra Set Sexy Wave Lace Women Underwear Seamless Comfortable Adjusted Bras Embroidery Lace Lingerie Panties Sets
aliexpress.com
$9.99
Woman Sportwear Top Bra Fitness 2 pieces Mesh Yoga Shirt+Bra Sexy Criss Cross Sports Top Women Active Wear Gym Clothing,ZF235
aliexpress.com
$16.42
polarized Outdoor Sport cycling Sunglasses MTB Mountain Bicycle Goggles s2 Cycling Glasses 100 Bike Eyewear Peter Gafas Ciclismo
aliexpress.com
$14.03
Unique Medusa Shirts Men Short Sleeve Floral Dress Shirts Fashion Golden Floral Print Lion Head Luxury Harajuku Summer Men Dress
aliexpress.com
$0.20
1Pc Black Liquid Eyeliner Pencil Long-lasting Waterproof Cat Style Eye Liner Pen Make-up Starry Eyes Make Up Tool Cosmetic TSLM2
aliexpress.com
$2.39
Fashion Luxury Sports Brand Tempered Glass Case for IPhone 6 S 6s 7 8 Plus X XS Xr Xs Max Xmax 10 Phone Case Back Cover Coque
aliexpress.com
$12.43
Girl Flower Princess Party Dress Graduation Performance Dresses For 3-8 Years Girls Elegant Customes Children Ball Gown Clothing
aliexpress.com
$4.08
HOMLIF Diamond Mosaic Painting tiger 5D Diy Diamond Painting Elf Full drill round Rhinestones Portrait Diamond Embroidery Animal
aliexpress.com
$2.59
Case For Xiaomi Redmi Note 6 5 Pro Case For Xiomi Pocophone F1 Case Stealth Bracket Holders Cover For Redmi 6 Pro 5 Plus 5A Case
aliexpress.com
$8.49
SAILEROAD 2 to 7years Cartoon Dinosaur Sweaters for Child Autumn Shirt for Boy O Neck Sweater Baby Newborn Clothes
aliexpress.com
$2.73
EMK Jack 3.5 Audio Cable 3.5mm Speaker Line Aux Cable for iPhone 6 Samsung galaxy s8 Car Headphone Xiaomi redmi 4x Audio Jack
aliexpress.com
$2.23
1 Pcs 1156 LED BA15S P21W 1157 BAY15D Bau15s Wedge 4 Cob Car Light White Brake Reversing Bulb Turn Signal DRL Tail Lamp DC 12V
aliexpress.com